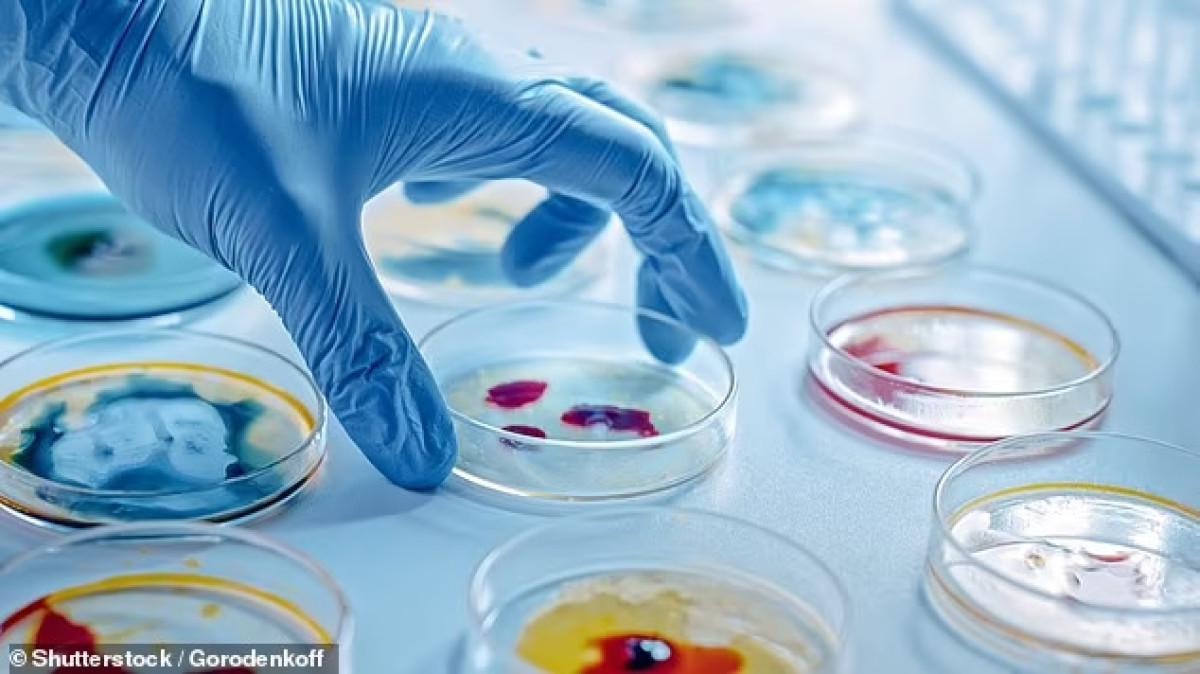

Çinli bilim insanları ağır semptomları olan mutant Ebola virüsü üretti
Çinli bilim insanları, laboratuvar ortamında mutant Ebola virüsü geliştirdi. Korkunç semptomlara neden olan bu virüs, farelerde ölüme neden oldu.
Dünya henüz koronavirüs pandemisinin yaralarını sararken Çinli bilim insanları, yine çok tartışılacak deneyler yapmaya devam ediyor.
Çinli araştırmacılar, bir laboratuvarda Ebola'nın bazı kısımlarını içeren ve bir grup fareyi öldüren bir virüs tasarladı.
Hebei Tıp Üniversitesi'ndeki bir araştırmacı ekibi, bulaşıcı bir hayvancılık hastalığını kullandı ve Ebola'da bulunan, virüsün hücreleri enfekte etmesine ve insan vücuduna yayılmasına izin veren bir protein ekledi.
Fareler organ yetmezliğinden öldü
Çalışmada, ölümcül enjeksiyon uygulanan hamster grubunun 'çoklu organ yetmezliği de dahil olmak üzere insan Ebola hastalarında gözlemlenenlere benzer ciddi sistemik hastalıklar geliştirdiği' ve sonunda öldükleri belirtildi.
Endişeler arttı
Deney başka bir laboratuvar sızıntısı korkusunu tetikleyebilirken, araştırmacılar hedeflerinin laboratuvar ortamında Ebola semptomlarını güvenli bir şekilde taklit edebilecek doğru hayvan modellerini bulmak olduğunu söylüyor.
Çalışma, enfekte farelerin gelecekte Ebola'nın yayılmasını ve tedavisini incelemek için iyi bir model olabileceğini öne sürdü.
Ebola'nın, çoğu yalnızca BLS-2 olan, özel yüksek güvenlikli laboratuvarlar olan Biyogüvenlik Seviye 4 (BSL-4) tesislerinde ele alınması gerekiyor.
Bilim insanları, daha düşük güvenlikli bir ortamda bu sorunu çözmek için, vesiküler stomatit virüsü (VSV) adı verilen farklı bir virüs kullandılar.
Ekip, hepsi üç haftalık olan beş dişi ve beş erkek hamster üzerinde çalıştı.

Farelerin çoğu öldü
Dişi farelerin tamamında rektal sıcaklıkta azalma ve yüzde 18'e kadar kilo kaybı görüldü; hepsi iki ila üç gün arasında öldü.
Beş erkek hamster, yüzde 15 kilo kaybetti ve en geç üç buçuk gün içinde hastalığa yenik düştü.
Ancak iki erkek hamster hayatta kaldı ve enfeksiyon öncesine göre yüzde 20 daha fazla kilo aldı.
Ekip, ölü hayvanlardan organ topladı ve virüsün kalp, karaciğer, dalak, akciğer, böbrek, mide, bağırsak ve beyin dokularında biriktiğini buldu.
Üretilen virüs, en yüksek seviyeler karaciğerde, en düşük seviyeler ise beyinde bulundu.
Ebola 11 binden fazla insanı öldürmüştü
Dünya Sağlık Örgütü'nün (DSÖ) bir raporuna göre, Ebola'nın son büyük salgını 2014 ile 2016 yılları arasında birçok Batı Afrika ülkesinde meydana geldi ve ölümcül oldu .
Bu iki yıl boyunca 28 bin 600'den fazla kişinin enfekte olduğu ve yaklaşık 11 bin 300 kişinin öldüğü bildirildi. Virüs Batı Afrika'dan Avrupa'ya ve hatta Amerika Birleşik Devletleri'ne yayıldı.

Bulaşıcı virüslerin test edilmesi, tedavi ve önlemedeki atılımlar için gereklidir. Ancak laboratuvarda sızıntılar meydana gelebiliyor ve bu olaylar, virüsün laboratuvar dışındakilere yayılmasına yol açabiliyor.
Mart ayında açıklanan veriler, laboratuvar sızıntısı olaylarının her yıl meydana geldiğini ve tüberküloz ve şarbon gibi kontrollü patojenlerin salınımını da içerdiğini ortaya çıkardı.
Şimdilik tehlike yok
New Jersey'deki Rutgers Üniversitesi'nden kimya biyoloğu Dr. Richard Ebright, Çinli bilim insanlarının kullandığı deney virüsünün halk arasında yaygın bir enfeksiyona yol açmasının pek olası olmadığını söyledi.